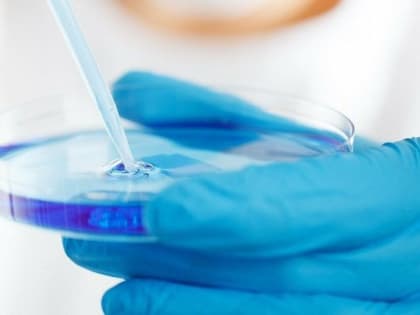

Происшествия

Во Владивостоке загорелось судно "Катерина Великая", есть погибшие
О количестве пострадавших пока не сообщается Модель судна "Катерина Великая" Фото: Сергей Лутов, fleetphoto.ru Ночью понедельника, 8 апреля, во Владивостоке загорелось судно "Катерина Великая", сообщает ИА PrimaMedia.

На Колыме пожарный извещатель спас многодетную семью
МАГАДАН. КОЛЫМА-ИНФОРМ. Утром в Сусумане загорелась двухкомнатная квартира на первом этаже.
Законопроект об ужесточении ответственности за провоз патогенов в Россию внесен в Госдуму
Ответственность за нарушение правил безопасности при обращении с опасными вирусами и токсинами будет ужесточена.

Спасатели и полицейские в Магадане предотвратили попытку суицида
МАГАДАН. КОЛЫМА-ИНФОРМ. Очевидцы сообщили, что на пятом этаже многоэтажного дома по ул.

Сильный ветер с метелью ожидают в Магаданской области 8 апреля
Существует угроза деформации и разрушения ледового поля припая Охотского моря, бухт Гертнера и Нагаева Тематическая иллюстрация Фото: MagadanMedia По информации ФГБУ "Колымское УГМС", 8 апреля в Магадане,

В Магадане спасатели и полицейские предотвратили необдуманный поступок
В Магадане спасатели и полицейские предотвратили попытку суицида Фото: пресс-служба Пожарно-спасательного центра Магаданской области Очевидцы сообщили,

Спасатели и полицейские в Магадане предотвратили попытку суицида
МАГАДАН. КОЛЫМА-ИНФОРМ. Очевидцы сообщили, что на пятом этаже многоэтажного дома по ул.

На Колыме полицейские подвели итоги оперативно-профилактического мероприятия «Мигрант – нарушитель»
В марте на территории Магаданской области проведено оперативно-профилактическое мероприятие «Мигрант – нарушитель».

Учения газоспасателей прошли в Магаданe
МАГАДАН. КОЛЫМА-ИНФОРМ. Спасатели поисково-спасательного отряда Главного управления МЧС России по Магаданской области провели занятия по работе с аварийными химическими отравляющими веществами.

Таганрожец зарезал двух магаданцев и потом вызвал полицию (Видео)
МАГАДАН. КОЛЫМА-ИНФОРМ. Первым отделом по расследованию ОВД СУ СК России по Магаданской области завершено расследование уголовного дела по обвинению 55-летнего таганрожца в совершении преступления, предусмотренного ч. 1 ст.